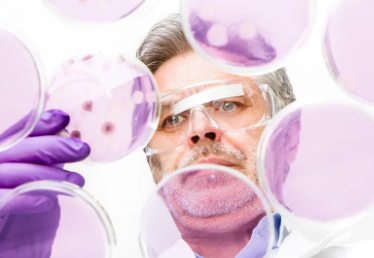
image.png

永康牙髓干細胞存儲費用是多少
2024-09-15 10:08:49 來源: 小編 咨詢醫(yī)生
在現(xiàn)今醫(yī)療技術飛速發(fā)展的背景下,牙髓干細胞存儲作為一種先進的生物存儲技術,受到了越來越多家庭的關注。尤其是在永康地區(qū),很多家長希望通過存儲牙髓干細胞,為孩子的未來健康保駕護航。然而,具體的存儲費用究竟是多少呢?在這篇文章中,我們將對永康牙髓干細胞存儲費用進行深入分析,為您提供詳盡的信息。
一、牙髓干細胞的來源與價值
首先,了解牙髓干細胞的來源及其醫(yī)學價值是十分重要的。牙髓干細胞來源于乳牙的牙髓組織,乳牙在自然脫落時或拔除后,可以提取牙髓,其中富含的干細胞具備多種分化能力,能夠轉化為不同類型的細胞。這些細胞在再生醫(yī)學、組織工程和細胞治療等領域顯示出巨大的潛力。因此,牙髓干細胞的存儲成為許多家庭未來健康規(guī)劃的一部分。
二、永康地區(qū)牙髓干細胞存儲費用構成
在永康,牙髓干細胞的存儲費用主要包括以下幾個方面:
1.采集費用:采集牙髓干細胞需要專業(yè)的牙科醫(yī)生進行操作,為了保障干細胞的質量,通常需要在醫(yī)院或專業(yè)機構進行。采集費用通常在800-2000元不等,具體根據(jù)醫(yī)院的資質和設備情況而有所差異。
2.處理費用:在采集后,牙髓干細胞需要經(jīng)過特定的處理和培養(yǎng),以確保其活性和存儲可行性。這一過程需要實驗室的專業(yè)設備和技術人員的操作,費用范圍一般在3000-5000元。
3.存儲費用:細胞處理完成后,需要存儲在低溫環(huán)境中,以保持細胞的活性。長期存儲的費用一般按年計算,通常為每年1000-2000元,大部分機構提供倉儲服務的合同時長為10年或更長。
4.額外服務費用:一些機構還提供額外的服務,如定期體檢、干細胞應用的咨詢等,這些費用根據(jù)服務內容的不同可能會有所變化。
三、影響費用的因素
有幾個要素會影響永康牙髓干細胞存儲的總費用,包括:
機構選擇:不同的醫(yī)療機構或生物樣本庫在技術、設備和專業(yè)水平上的差異,可能導致存儲費用的不同。
市場競爭:隨著越來越多的家庭意識到牙髓干細胞存儲的重要性,市場競爭也在增加,這可能導致部分機構采取促銷活動,從而影響價格。
服務內容:如果選擇更為全面的服務包,雖然初期投入較高,但長遠來看可能更具性價比。
四、總結
總體來看,永康牙髓干細胞存儲的費用通常在5000元到一萬元左右,具體費用需要根據(jù)所選擇的機構和服務項目的不同而有所變化。存儲牙髓干細胞是為未來健康投資的一種方式,盡早做出規(guī)劃,能夠為您和您的家庭提供更多保障。
在選擇存儲機構時,不僅要關注費用,還要重點考察機構的資質和技術水平,以確保所存儲的干細胞能夠在未來發(fā)揮最大的治療潛力。希望這篇文章能幫助大家對永康牙髓干細胞存儲費用有更清晰的認識。
-
上一頁: 國內牙髓干細胞存儲機構名單匯總
-
下一頁: 無錫人體干細胞存儲公司,內附機構名單
- 2024-09-24江西生物干細胞存儲方法和原理
- 2024-09-24陜西生物干細胞存儲公司有哪些
- 2024-08-06臍帶間充質干細胞存儲,臍帶間充質干細胞有必要保存嗎
- 2024-08-19臍帶干細胞保存有必要嗎,是不是智商稅
- 2024-10-26上海孟超干細胞存儲:怎樣確保安全存儲?
- 2024-10-29干細胞存儲過程需要注意哪些事項?
- 2024-08-02自體干細胞療法,自體干細胞移植需要多少錢
- 2024-09-27廣州貝拉國際干細胞是醫(yī)院嗎
- 2024-09-05干細胞采集的詳細過程,干細胞是如何提取的
- 2024-09-14肝癌的干細胞療法能治愈嗎,干細胞調治肝癌的潛力分析
- 2024-09-01干細胞肺癌治療臨床效果評估
- 2024-08-21干細胞去皺紋價格有副作用嗎
- 2024-08-15腸癌干細胞療法能治愈嗎
- 2024-09-07干細胞研究的前景怎么樣,干細胞治療的前景和現(xiàn)狀
- 2024-08-02做干細胞移植要多少錢,做干細胞移植手術有風險嗎
- 2024-09-26干細胞是活細胞嗎,其治療有效性如何評估和驗證
- 2024-08-26人體干細胞美容效果好嗎,解讀干細胞美容利弊
- 2024-09-25自體脂肪干細胞填充價格多少,填充費用一覽
